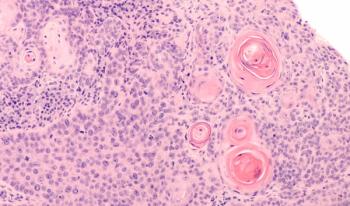

Nikita Dahake, MD; Hossein Borghaei, DO, MS; and Yasmine Baca, MS, PhD candidate, MB(ASCP)CM, explore how distinct HER2-alteration subtypes in non-small cell lung cancer (NSCLC) impact survival outcomes, co-mutation profiles, and treatment response to immunotherapy-based regimens.